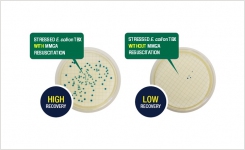
Resuscitation of Stressed and Injured E coli
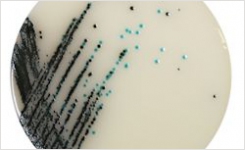
Chromogenic Agar for Salmonella Esterase

Neogen Culture Media
Formerly known as Lab M
Address
Heywood
United Kingdom
Contact Details
Visit Website +44 (0)1292 525629Neogen specialises in the development and production of microbiological culture media through Neogen Culture Media supporting compliance with global referencing methods including ISO, BAM and MLG. With an international reputation for high quality culture media products, Neogen has a particular focus on an expanding line of unique and innovative chromogenic agar formulations. Neogen Culture Media has a global presence with dual manufacturing sites in the UK and USA offering the same high quality products and service, wherever in the world you may be.
As reference standards are routinely updated and advances in technology allow for more efficient protocols, development and improvement of the Neogen Culture Media product range continues to ensure you have the most up to date and relevant product formulations to suit your methods.
Neogen Culture Media offers more than 270 dehydrated culture media (DCM) formulations designed to support many industries with their testing including food, water, pharmaceutical and clinical. Alongside a core range of DCM Neogen also offers convenience testing formats such as our ready-to-use prepared media and products to support innovative alternative testing method workflows.
The Neogen Culture Media product range includes:
- Harlequin® Chromogenic Media
- Pre-Poured Media Plates
- μPREP® Ready-to-Reconstitute Media
- EZ Prep Pre-weighed Media Pouches
- Captivate™ Immunomagnetic Separation (IMS) Beads
Neogen’s Heywood site is certified in accordance to ISO 9001:2015 & ISO 13485:2003 for design, manufacture and supply of microbiological culture media, antibiotic supplements and in-vitro diagnostic products. Products for the clinical market are supplied in compliance with the European IVD directive and carry the CE mark. Neogen Heywood's QC laboratory also holds ISO 17025:2005 accreditation from UKAS for the physical and microbiological performance testing methods of ready-to-use pre-poured plate range.
For more information, contact Neogen Culture Media today